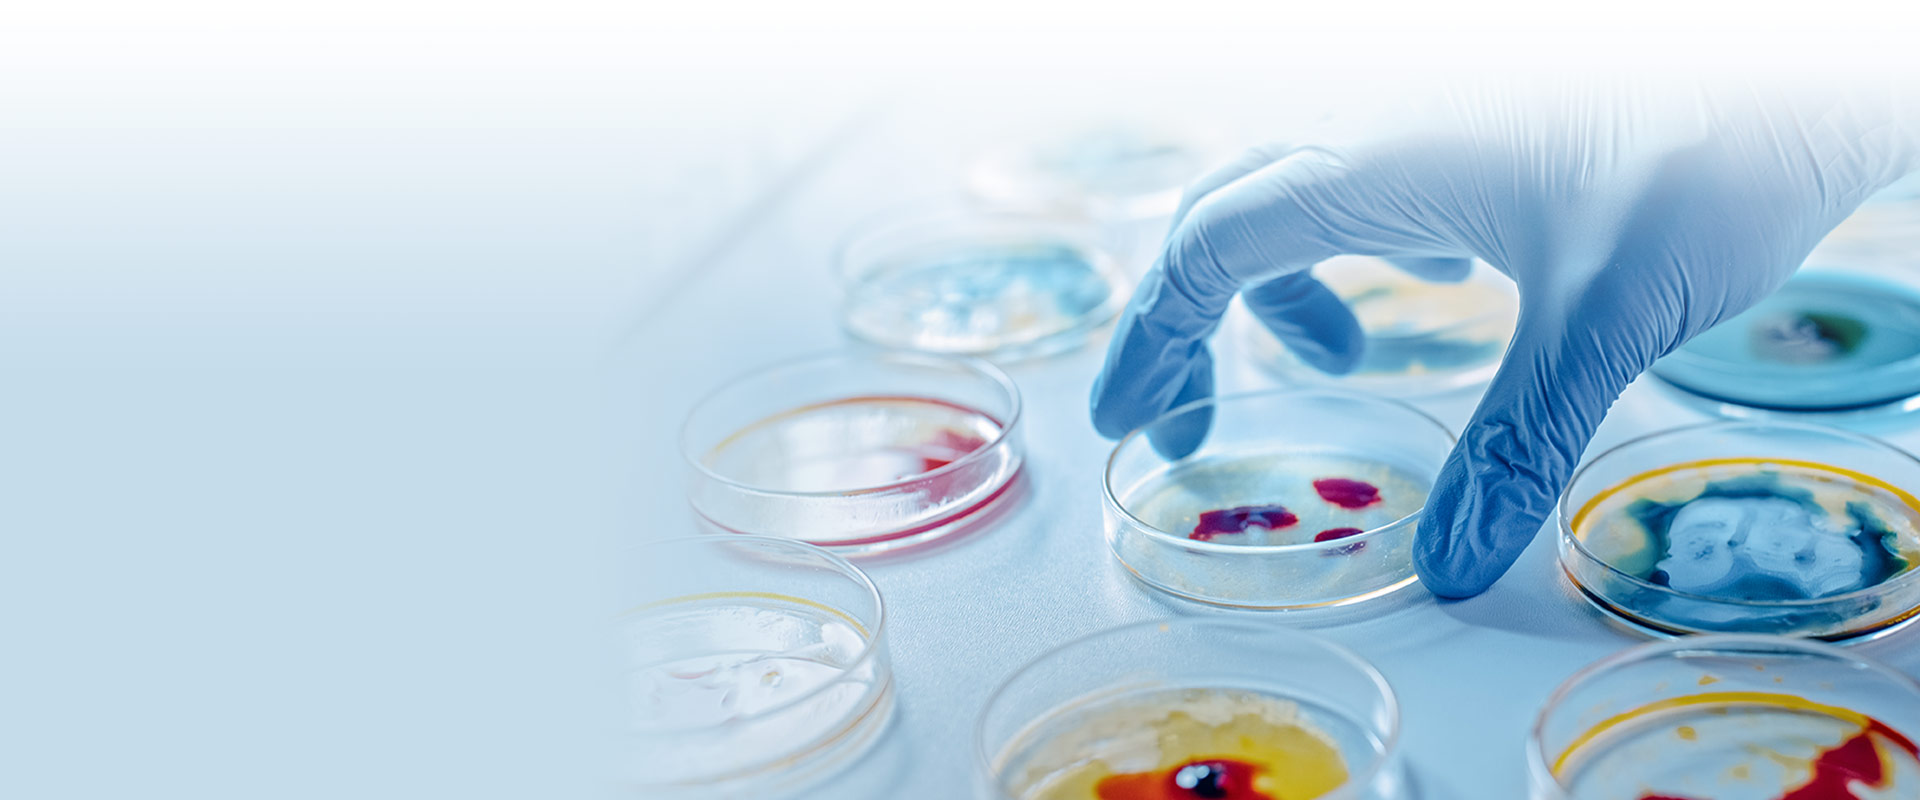

Who We Are
Venbriss healthcare is a highly focused pharmaceutical company dedicated to delivering quality medicines to patients in need through excellence in innovation, development, and manufacturing. For over 10 years, we have been partnering with key players in the health care industry and working every day...
Our Brands
Venbriss healthcare markets a broad portfolio of medicinal products for the patients suffering from various diseases.
Brands
Our Partners
Our partners who produce very unique and high quality products.